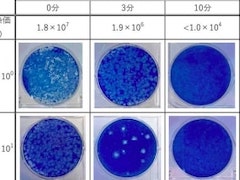
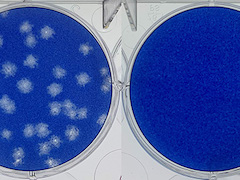

MONOist >
医療機器 記事一覧(2022年3月)
MONOistの医療機器についてのページです。医療機器に関する最新記事を掲載しています。(2022年3月)
- 2026年3月
- 2026年2月
- 2026年1月
- 2025年12月
- 2025年11月
- 2025年10月
- 2025年9月
- 2025年8月
- 2025年7月
- 2025年6月
- 2025年5月
- 2025年4月
- 2025年3月
- 2025年2月
- 2025年1月
- 2024年12月
- 2024年11月
- 2024年10月
- 2024年9月
- 2024年8月
- 2024年7月
- 2024年6月
- 2024年5月
- 2024年4月
- 2024年3月
- 2024年2月
- 2024年1月
- 2023年12月
- 2023年11月
- 2023年10月
- 2023年9月
- 2023年8月
- 2023年7月
- 2023年6月
- 2023年5月
- 2023年4月
- 2023年3月
- 2023年2月
- 2023年1月
- 2022年12月
- 2022年11月
- 2022年10月
- 2022年9月
- 2022年8月
- 2022年7月
- 2022年6月
- 2022年5月
- 2022年4月
- 2022年3月
- 2022年2月
- 2022年1月
- 2021年12月
- 2021年11月
- 2021年10月
- 2021年9月
- 2021年8月
- 2021年7月
- 2021年6月
- 2021年5月
- 2021年4月
- 2021年3月
- 2021年2月
- 2021年1月
スポンサーからのお知らせPR
Special ContentsPR
おすすめ技術資料PR
Special SitePR